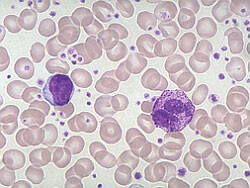

Среда обитания
Тромбоциты начинают формироваться в мегакариоцитах, которые представляют собой крупные клетки, находящиеся в костном мозге. Их диаметр варьируется от 60 до 120 мкм. В зрелом состоянии мегакариоциты обладают обширной цитоплазмой, фиолетово-розовыми гранулами и крупным ядром с неопределенной формой.
На данном этапе из цитоплазмы отделяются мелкие фрагменты. Около одной трети из них остается в селезенке, в то время как остальные попадают в общий кровоток. Задержка в селезенке происходит из-за медленного движения через неровные структуры органа. Поэтому при заболеваниях селезенки наблюдается снижение общего уровня тромбоцитов в крови.
Врачи отмечают, что тромбоциты играют ключевую роль в процессе свертывания крови и поддержании гемостаза. Средняя продолжительность жизни тромбоцитов составляет около 7-10 дней, после чего они разрушаются в селезенке и печени. Нормальный уровень тромбоцитов в крови варьируется от 150 до 450 тысяч клеток на микролитр. Снижение их количества может указывать на различные заболевания, включая тромбоцитопению, которая может быть вызвана как аутоиммунными процессами, так и инфекциями. Врачи подчеркивают важность регулярного мониторинга уровня тромбоцитов, особенно у пациентов с предрасположенностью к тромбообразованию или кровотечениям. Правильная диагностика и лечение могут предотвратить серьезные осложнения.

Разновидность тромбоцитов
При проведении анализа крови внимание уделяется только зрелым клеткам, которых в организме здорового человека насчитывается около 90%. Однако существуют и другие типы тромбоцитов:
- Молодые тромбоциты, которые по своим размерам превышают зрелые. Если их количество увеличивается, это может свидетельствовать о том, что костный мозг функционирует на пределе, особенно в случае значительной потери крови.
- Старые тромбоциты, которые характеризуются тонким ободком по краю и увеличенным количеством гранул. Их наличие может указывать на развитие злокачественных опухолей.
- Формы с признаками раздражения можно определить по их увеличенному размеру и аномальной форме. Эти клетки возникают в результате нарушений в процессе отшнуровки тромбоцитов при различных заболеваниях крови.
| Параметр | Значение | Единицы измерения/Примечания |
|---|---|---|
| Продолжительность жизни тромбоцитов | 7-10 дней | В среднем |
| Норма тромбоцитов в крови (взрослые) | 150 000 — 450 000 | × 10⁹/л (клеток на литр) |
| Норма тромбоцитов в крови (дети) | Зависит от возраста, консультируйтесь с врачом для уточнения | × 10⁹/л (клеток на литр) |
Структура тромбоцитов
Зрелые тромбоциты имеют форму диска с четкими границами, их размер в среднем составляет от 2 до 5 мкм. Эти клетки не содержат ядра, но в их составе присутствует грануломер, состоящий из небольшого количества азурофильных гранул — от 5 до 20 на одну клетку.
При проведении среза можно выделить три зоны строения тромбоцита:
- Периферическая зона. В этой области находится надмембранный участок, который играет ключевую роль в активации тромбоцитов. Мембрана необходима для обеспечения быстрой и корректной реакции на свертывание крови.
- Отдел органелл включает четыре типа гранул. Их основная задача — накапливать факторы, отвечающие за свертываемость крови. Эта функция сохраняется активной на протяжении длительного времени, несмотря на короткий срок жизни тромбоцитов у человека.
- Зона «золь-гель». Главным компонентом этой области являются митохондрии. Благодаря окислительно-восстановительным процессам в них выделяется энергия, которая питает клетку и обеспечивает ее подвижность.
Тромбоциты, или кровяные пластинки, играют ключевую роль в процессе свертывания крови. Их продолжительность жизни составляет всего 7-10 дней, после чего они разрушаются в селезенке и печени. Нормальный уровень тромбоцитов в крови варьируется от 150 до 450 тысяч на микролитр. Отклонения от этих значений могут указывать на различные заболевания. Например, низкий уровень тромбоцитов, известный как тромбоцитопения, может привести к повышенному риску кровотечений, тогда как высокий уровень, тромбоцитоз, может быть связан с воспалительными процессами или даже онкологией. Люди часто недооценивают важность этих клеток, однако их здоровье напрямую зависит от правильного функционирования тромбоцитов. Регулярные анализы крови помогают контролировать их уровень и предотвращать возможные осложнения.

Жизненный цикл и функциональность
После завершения процесса отделения от мегакариоцита, тромбоциты живут в среднем от 7 до 11 дней. Однако их активность и функциональные способности постепенно уменьшаются. Наибольшее скопление и последующее разрушение тромбоцитов происходит в печени и селезенке.
Тромбоциты обладают разнообразными функциями и уникальными характеристиками. Благодаря рецепторам они способны прилипать к поврежденным участкам, что называется адгезией.
Когда тромбоциты взаимодействуют с коллагеном, находящимся в эндотелии, в их цитоплазму поступают ионы, открывающиеся через кальциевые каналы. Это запускает активацию клеток, в результате чего они изменяют свою форму и размер.
Затем наступает фаза агрегации, в ходе которой формируется тромб. Он не только останавливает кровотечение, но и благодаря своей плотной структуре предотвращает проникновение вредных бактерий в организм.
Норма тромбоцитов в крови человека
Среднее время, необходимое для созревания одного мегакариоцита, составляет 5 дней. По истечении этого периода он выделяет примерно 3000 тромбоцитов. У взрослого человека нормальный уровень тромбоцитов в крови несколько выше, чем у детей, и находится в пределах 150–350 x 10^9 /л; для малышей оптимальным считается диапазон 150–250 x 10^9 /л.
Эти показатели являются относительными и могут изменяться в зависимости от пола, возраста и наличия различных заболеваний. Существенные колебания в количестве тромбоцитов могут указывать на развитие какого-либо заболевания.
https://youtube.com/watch?v=2V4VWIiBKac
О чем говорит изменение количества тромбоцитов
Тромбоцитопения
Анализ крови, взятый из пальца, позволяет получить общее представление о состоянии здоровья. Снижение уровня тромбоцитов указывает на тромбоцитопению, которая может возникать по следующим причинам:
- Заболевания крови, такие как лейкоз или анемия.
- Наличие инфекционных процессов в организме.
- Генетическая предрасположенность.
- Проблемы с функционированием костного мозга или почек.
Кроме того, у женщин уровень тромбоцитов может снижаться в результате гормональных изменений, например, во время менструации или беременности.
Некоторые медикаменты и алкоголь также могут оказывать влияние на уровень тромбоцитов.
При тромбоцитопении существует риск внутреннего кровотечения, так как сосуды становятся более хрупкими и теряют эластичность. Рекомендуется пройти обследование при первых симптомах, таких как:
- Частое появление крови при чистке зубов.
- Синяки, возникающие от легких ударов.
- Длительное кровотечение при небольших порезах.
- Частые носовые кровотечения.
- Обильные и продолжительные менструации.
После тщательного обследования врач назначает соответствующее лечение. Однако, если результаты не удовлетворительные, единственным вариантом может стать удаление селезенки.
Тромбоцитоз
Увеличение уровня тромбоцитов указывает на их активное производство, что может привести к образованию тромбов. Это может происходить по следующим причинам:
- Воспалительные процессы в органах.
- Заболевания, такие как туберкулез и цирроз.
- Наличие онкологических заболеваний.
- Перенесенные кровотечения, в том числе после операций.
- Применение медикаментов, включая кортикостероиды.
- Заболевания системы кровообращения.
- Хирургическое вмешательство по удалению селезенки.
Тромбоциты играют ключевую роль в поддержании здоровья человека. Поэтому важно понимать, как долго они живут и как предотвратить как их снижение, так и повышение уровня в крови.
Вопрос-ответ
Как долго живут тромбоциты?
Тромбоциты — это небольшие фрагменты клеток. Их основной функцией является остановка кровотечения. Они составляют очень малую часть от общего объема крови (менее 1 %). Продолжительность жизни тромбоцитов — около 9–12 дней.
Как долго тромбоциты живут в крови?
Тромбоциты — это форменные клетки крови, которые в первую очередь отвечают за ее свертываемость. Они образуются в костном мозге из мегакариоцитов, созревают около недели, а живут не более 10 дней.
Какой показатель тромбоцитов считается опасным?
Чем опасен тромбоцитоз — повышенный уровень тромбоцитов? Наиболее опасен уровень тромбоцитов выше 800 млн на литр — он создаёт угрозу закупорки сосудов тромбами (тромбозов). Результатом может стать инфаркт миокарда, инсульт и другие сердечно-сосудистые патологии.
Какова норма тромбоцитов по возрасту?
Норма тромбоцитов может незначительно меняться в зависимости от возраста мужчины: молодые мужчины (18-44 года) — 150-400 × 10⁹/л, мужчины среднего возраста (45-64 года) — 150-380 × 10⁹/л, мужчины пожилого возраста (65 лет и старше) — 140-380 × 10⁹/л.
Советы
СОВЕТ №1
Регулярно проходите медицинские обследования, чтобы контролировать уровень тромбоцитов в крови. Это поможет выявить возможные отклонения на ранних стадиях и предотвратить серьезные заболевания.
СОВЕТ №2
Обратите внимание на свое питание. Включайте в рацион продукты, богатые витаминами B12 и K, а также железом, которые способствуют нормальному образованию тромбоцитов. Это могут быть зеленые листовые овощи, мясо, рыба и бобовые.
СОВЕТ №3
Избегайте стрессов и физических перегрузок. Хронический стресс может негативно сказаться на состоянии вашей крови, включая уровень тромбоцитов. Практикуйте методы релаксации, такие как йога или медитация.
СОВЕТ №4
Если у вас есть заболевания, влияющие на уровень тромбоцитов, такие как диабет или заболевания печени, следите за их лечением и соблюдайте рекомендации врача. Это поможет поддерживать здоровье вашей крови в норме.